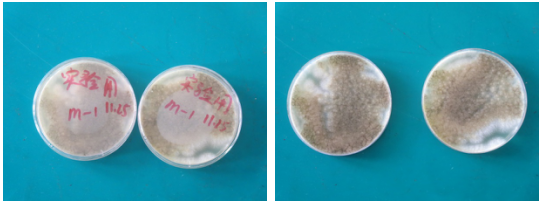

海博微信公众号
海博微信公众号
 海博天猫旗舰店
海博天猫旗舰店


 海博微信公众号
海博微信公众号
 海博天猫旗舰店
海博天猫旗舰店




一、 实验名称:
即用型TSA平皿霉菌的辐照效果实验
二、 实验目的:
检测辐照灭菌对霉菌的灭菌效力。
三、 实验原理:
1. 人工在主动在TSA平皿表面接种高浓度霉菌,辐照灭菌后培养,观察霉菌生长状况来判断辐照灭菌效力。
四、 实验步骤:
实验一:
1. 取即用型9cm TSA平板两组,7.5cmTSA平板一组,5.5cmTSA平板一组,对照TSA一组(不辐照直接培养)。
2. 在每个平板表面分别接种10-1的霉菌菌液100μL,用与产品工艺相同的包装方式将平皿包装并抽真空。
3. 样品组辐照灭菌,对照组直接培养。
4. 将辐照后的平皿放入37℃空培养3天,再在25℃培养3天,观察结果。
五、 实验结果:
实验一:
对照组:平皿整个平板长满霉菌,如图一所示。
图一、对照组
实验组:四组平皿均未有霉菌生长,如图二、图三、图四、图五所示。

图二、实验组9cm平皿1 图三、实验组9cm平皿2

图四、实验组7.5cm平皿 图五、实验组5.5cm平皿
六、 结论:
本公司的辐照灭菌工艺可以完全彻底地将霉菌杀死,若有平皿被霉菌污染,辐照灭菌应该不是平皿污染的主要原因。



